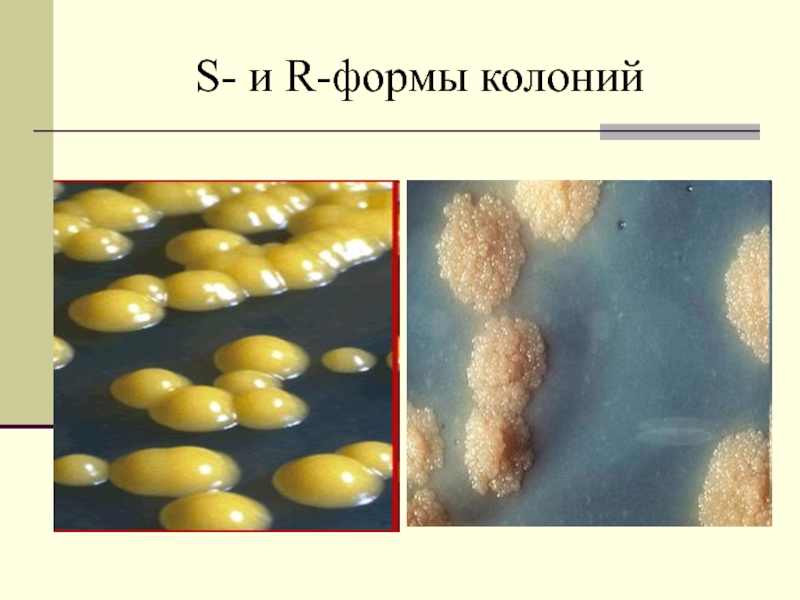

Слайд 1Бактериальная клеточная стенка
СПбГУ
2011
Слайд 2План лекции
1. Строение пептидогликана (ПГ) клеточной стенки
2. Особенности строения и
синтеза пептидной части ПГ
3. Пенициллин и его действие на
ПГ
4. Действие лизоцима и литических ферментов на ПГ
5. Функция ПГ
6. Две эволюционные ветви: Гр- и Гр+ бактерии. Окраска по Граму
7. Особенности строения клеточной стенки Гр+ бактерий
8. Особенности строения клеточной стенки микобактерий
9. Особенности строения клеточной стенки Гр- бактерий
10. Белки внешней мембраны клеточной стенки Гр- бактерий
Слайд 31вопрос. Строение пептидогликана (ПГ) клеточной стенки
ПГ = муреин от лат.
Murus - стена
ПГ - гетерополимер
ПГ – сложный комплекс, состоящий
из 2-х частей:
1. гликановая часть
2. пептидная часть
Слайд 4Гликановая часть ПГ
состоит из 2-х аминосахаров (АС)
АС соединены 1,4β гликозидной
связью
N-ацетилглюкозамин
N-ацетилмурамовая кислота
1
4
β
Слайд 52 вопрос.
Особенности строения и синтеза пептидной части ПГ
Пептидная часть –
4 АК = тетрапептид
К 3 атому а N-АМК присоединена
лактинная
группировка, к ней тетрапептид
-ОН - лактин, =О - лактам
Слайд 6Пептидная часть ПГ
L-аланин
D- глутаминовая кислота
мезо-диаминопимелиновая кислота (ДАПК)
D-аланин
Слайд 7Особенности синтеза пептидной части
АК ПГ у бактерий в Д-форме.
У
эукариот большинство АК в L-форме.
Синтез ПГ бактерий происходит в цитоплазме.
Синтез пептидной части не связан с рибосомами - происходит за счет ферментов.
У бактерий специфические тРНК доставляют АК к месту синтеза.
тРНК специфически связываются с АК в Д-форме.
Состав пептидов в ПГ очень консервативен.
Сначала происходит сборка так называемого «кирпичика»: N–АМК+4АК+N–АГА.
«кирпичик» крепится на ЦПМ, потом встраивается в цепочку ПГ следующим образом:
Слайд 9Однослойная структура пептидогликана
Слайд 10Типы связей в молекуле ПГ
1. Гликозидная
2. пептидные
3. пентаглициновые (у Гр+)
Строение
ПГ необходимо учитывать при создании новых АМП
ПГ – основная мишень
для АМП у бактерий
Слайд 113 вопрос.
Пенициллин и его действие на ПГ
Пенициллин – А.
Флеминг 1928 г.
Род Penicillium
Действует на
пентаглициновые мостики между гетерополимерными цепочками
у Гр+ бактерий
и
пептидные мостики между гетерополимерными цепочками у Гр- бактерий
Слайд 12Пептидные (у Гр-) и пентаглициновые (у Гр+) мостики между гетерополимерными
цепочками пептидной части ПГ
Г
М
L-ала
D-ала
Мезо-ДАП
D-глу
Г
М
L-ала
D-ала
Мезо-ДАП
D-глу
Г
М
L-ала
D-ала
Мезо-ДАП
D-глу
Г
М
L-ала
D-ала
Мезо-ДАП
D-глу
гли
гли
гли
гли
Гр+
Гр-
Е.сoli
Слайд 13 Александр Флеминг
1881–1955
Английский бактериолог, Нобелевская премия по физиологии
и медицине 1945 г.
за открытие пенициллина
(1928).
Слайд 14Уязвимое место молекулы пенициллина и цефалоспорина - действует фермент бета-лактамаза
Слайд 154 вопрос. Действие лизоцима и литических ферментов на ПГ
Флеминг изучал
способы разрушения бактерий.
Micrococcus lysodeikticus
Биологические жидкости:
слезная жидкость,
слизистые выделения носовой полости,
урогенитального тракта,
яичный
белок,
выделения потовых желез
Слайд 16ЛИЗОЦИМ (мурамидаза) - фермент класса гидролаз
Разрушает β-1,4-гликозидную связь между
N-АГА
и N-АМК ПГ
1
4
β
Слайд 17Лизоцимоподобные ферменты
Эндопептидаза
Бактериоцины
Слайд 18Функции лизоцимоподобных ферментов
1.В процессе роста для вставки (импрегнации) в клеточную
стенку новых вновь синтезированных фрагментов ПГ.
Ферментативное разрушение ПГ идет
только в определенных участках клеточной стенки.
2. Бактерии вырабатывают подобные ферменты для борьбы с другими бактериями.
3. Бактерии обладают устойчивостью к действию своих собственных ферментов (иммунитет).
4. Некоторые молекулы подобных ферментов способны свободно проникать через ПГ в просветы диаметром около 2 нм.
5. Свободно проникают молекулы с Мм ~50 кДа.
Слайд 19Основная функция – стабильность – поддержание постоянной формы бактерии
Иммунологические функции:
иммуномодулятор, запускает классический и альтернативный пути активации системы комплемента.
Тормозит фагоцитарную
активность макрофагов.
Угнетает миграцию макрофагов.
Обладает противоопухолевым действием.
5 вопрос. Функции ПГ :
Слайд 206. Вопрос. Окраска по Граму
2 группы:
1. Firmicutes – грамположительные бактерии
2.
Gracilicutes – грамотрицательные бактерии
Слайд 21Окраска по Граму
Ганс Христиан Грам
(1853–1938)
Датский бактериолог
1884 г. -
предложил новый метод
окраски бактерий
Слайд 22Две эволюционные линии бактерий
1. Firmicutes – грамположительные бактерии
2. Gracilicutes –
грамотрицательные бактерии
Слайд 247 вопрос. Особенности строения клеточной стенки Гр+ бактерий
Слайд 25Гр+ тип строения клеточной стенки клетки Staphylococcus aureus
Слайд 26Структура пептидогликана
Гр+ бактерий. ПГ – 90% от массы клеточной
стенки.
ПГ не однослойный, расположен в 5, 6 слоев
Слайд 27Тейхоевая кислота
1. полимеры - сложные комплексы многоатомных спиртов с сахарами,
АК и фосфатами.
2. определяет антигенные свойства
3. связывает ионы магния
и кальция
4. регуляторы ПЦ-связывающих белков
Слайд 28Поверхностные компоненты Гр+ бактерий
Белок А
Белок М
Иммунологическая мимикрия
Слайд 298 вопрос. Особенности строения клеточной стенки микобактерий
В клеточной стенке
Mycobacterium tuberculosis
60-90% липидов (в среднем у бактерий 2-8%)
Липиды микобактерий:
миколовые кислоты,
воск Д,
корд-фактор – трегалоза-6,6-димиколат.
Метод окраски микобактерий – Циля-Нильсена
Слайд 309 вопрос. Гр- тип строения клеточной стенки Ультратонкий срез клетки
Escherichia coli
Слайд 31Особенности строения клеточной стенки Гр- бактерий
А. Клеточная стенка грамотрицательных бактерий:
1 — цитоплазматическая мембрана; 2 — пептидогликановый слой;
3 —
периплазматическое пространство; 4 — молекулы белков (заштрихована гидрофобная часть); 5 — фосфолипид;
6 — липополисахарид.
Б. Строение молекулы липополисахарида: 1 — липид А;
2 — внутреннее полисахаридное ядро; 3 — наружное полисахаридное ядро; 4 — О-антиген
Слайд 32Особенности строения клеточной стенки Гр- бактерий
Слайд 34S- и R-формы колоний B. anthracis
rough form (шероховатая)
smooth form (гладкая)
Слайд 36Схема эксперимента Гриффита (по Стенту)
Слайд 3710 вопрос. Белки внешней мембраны клеточной стенки Гр- бактерий
1. белки-адгезины,
2.
белки-порины: диаметр пор omp C = 1,1; omp F =1,2
нм,
3. белки-переносчики витамина В12,
4. белки-переносчики железа,
5. белки-рецепторы для бактериофагов.
Слайд 38Белки внешней мембраны клеточной стенки Гр- бактерий.